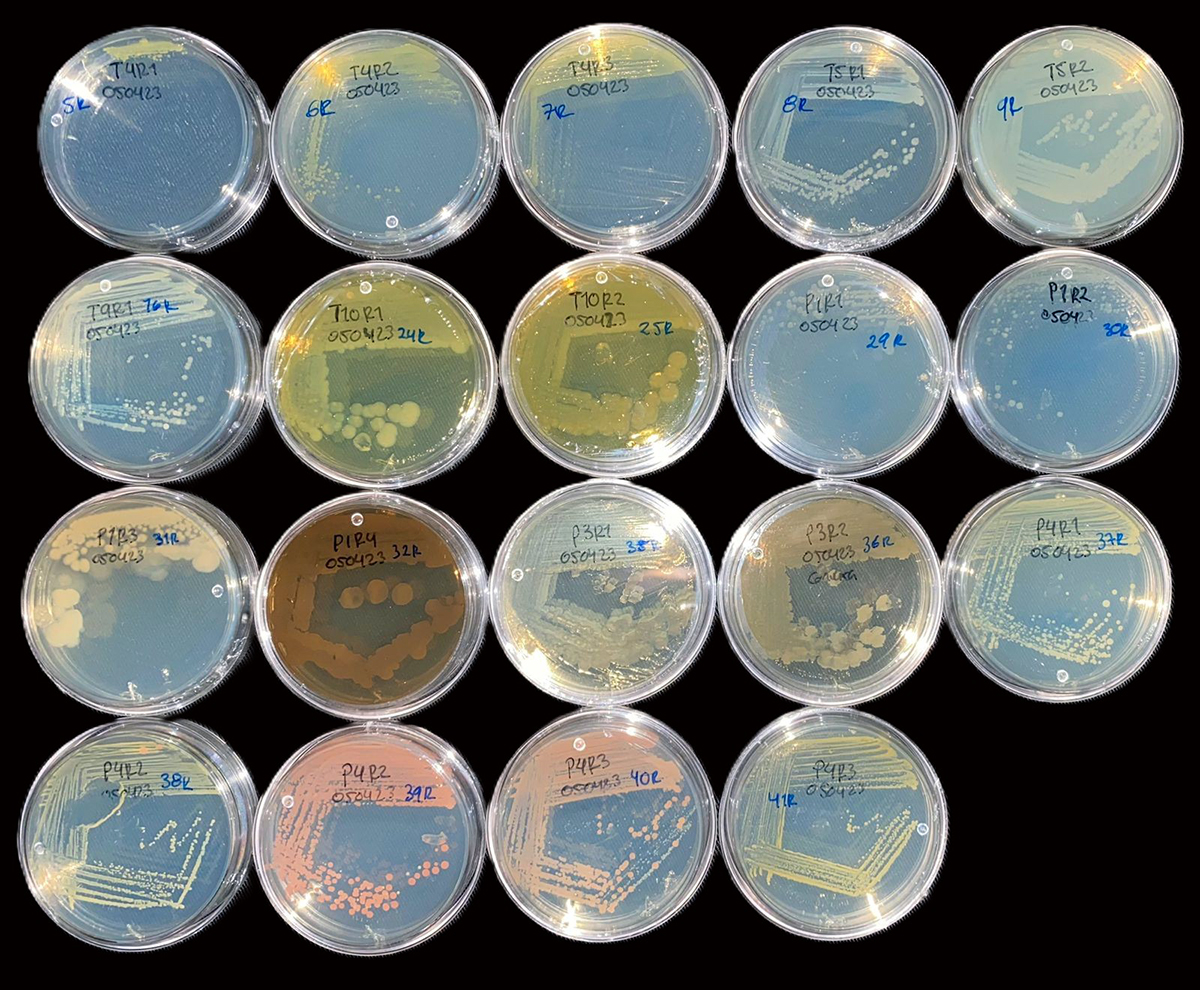

Biodiversidad y el control de plagas
J. Francisco Castillo Esparza, Damaris Desgarennes y Gloria Carrión*

En los agroecosistemas algunos microorganismos benéficos mantienen el control de plagas, con el estudio y su selección se pueden elaborar bioinsumos para la agricultura sostenible.
De manera natural las diferentes poblaciones de plantas, animales, insectos, hongos y bacterias están rodeados de organismos que llamamos “enemigos naturales”, todos ellos conforman un entramado complejo de interacciones (biodiversidad) que mantienen las poblaciones en perfecto balance en los ecosistemas. Dentro de las plantas, los cultivos agrícolas se ven afectados por diferentes enfermedades y ataques ocasionados principalmente por microorganismos e insectos, sin embargo, las plantas cuentan con una comunidad de microorganismos (microbioma) que ayudan a protegerlas de enfermedades y de la herbívora causada por insectos, además cuentan con microorganismos aliados que son enemigos naturales de sus patógenos, mejor conocidos como agentes de control biológico.
Algunos ejemplos de microorganismos que han mostrado ser aliados de las plantas son los hongos entomopatógenos, principalmente del género Beauveria, Metarhizium, Lecanicillium, Isaria, Cordyceps, Hirsutella, etc., [1] los cuales causan epizootias en insectos que afectan cultivos de importancia económica, como son el gusano blanco de la papa (Premnotrypes vorax), el barrenador de ramas del cafeto (Xylosandrus spp.), el psílido asiático de los cítricos (Diaphorina citri) (Fig. 1), el pulgón amarillo del sorgo (Melanaphis sacchari), la mosca blanca (Bemisia tabaco), la broca del café (Hypothenemus hampei), el barrenador europeo del maíz (Ostrinia nubilalis), por mencionar algunos. Por otra parte, también hay ejemplos de éxito en el control de enfermedades e insectos plagas a través del uso de diferentes especies de bacterias (Fig. 2) como Streptomyces spp., Bacillus subtilis y B. thuringiensis o las rizobacterias Pseudomonas fluorescens y P. protegens que promueven el crecimiento de las plantas, además de funcionar como biocontroladores. Aunque algunas de estas especies de hongos y bacterias ya han sido comercializadas, aún se requieren esfuerzos para aumentar la disponibilidad de biopesticidas microbianos eficaces para el control de enfermedades y plagas de las plantas, mediante la búsqueda de nuevas cepas de hongos y bacterias con mayor virulencia [2].

Figura 1. Diaphorina citri infectada por un hongo entomopatógeno
Los numerosos casos de éxito utilizando tanto bacterias como hongos en el control de enfermedades y plagas, ha favorecido la generación de insumos biológicos, los cuales han sido utilizados en diversos cultivos de importancia económica, por lo cual, en los últimos años se ha intensificado el desarrollo específico de biopesticidas (biofungicidas, bioinsecticidas, bionematicidas y biobactericidas). Sin embargo, algunos microorganismos han demostrado tener algunas actividades biológicas adicionales al control de plagas, lo cual hace que sean más atractivos para ser utilizados en el desarrollo de bioinsumos. Entre ellos tenemos los bioinsumos utilizados como promotores de crecimiento y desarrollo vegetal (biofertilizantes y bioestimulantes) y los usados en el acondicionamiento o restauración del suelo (biorremediadores, biorestauradores y biotransformadores). Todos estos bioinsumos están siendo reconocidos como una opción a implementar para mantener una agricultura sostenible, libre de sustancias tóxicas para el medio ambiente, los agricultores y los consumidores.
Sin embargo, antes de llegar a proponer un microorganismo como agente de control biológico, es necesario evaluar y considerar diferentes aspectos a nivel de laboratorio, invernadero y campo con la finalidad de determinar su eficacia. En el caso de los hongos, en México el Centro Nacional de Referencia de Control Biológico (CNRCB) ha desarrollado estrategias para mitigar diversas plagas de importancia agrícola, las cuales incluyen la búsqueda y colecta en campo, ensayos de selección de cepas virulentas, producción y formulación, pruebas de seguridad biológica sobre insectos no blanco y mamíferos, evaluación de equipos de aplicación y de la efectividad biológica en campo [3]. Para la selección de un agente de control bacteriano es necesario considerar aspectos como mecanismo de acción, acondicionamiento, dosis, métodos de aplicación, sensibilidad, tipo de cultivar, propiedades físicas y las condiciones ambientales [2]. Una vez evaluados los microorganismos en condiciones de laboratorio, se realizan experimentos en invernadero para probar dosis y tiempos de acción del agente de control biológico. El establecimiento de pequeñas parcelas a nivel de campo es una de las etapas cruciales para hacer las pruebas del bioinsumo en un entorno real. Superadas estas etapas de la investigación y logrando seleccionar un microorganismo que supere todas las pruebas de laboratorio, invernadero y campo, se puede llegar a la fase de escalamiento de un producto que pueda considerarse como un prototipo.
Figura 2. Diferentes especies de bacterias con potencial biológico
Como se ha mencionado, para desarrollar un bioinsumo se requiere de mucha paciencia esfuerzo y dedicación; pero, sobre todo, se requiere de muchas pruebas a nivel de laboratorio, invernadero y campo, siguiendo una metodología rigurosa para poder llegar al desarrollo de un bioinsumo de calidad. El INECOL es uno de los Centros de Investigación de la SECIHTI, en el cual, a través de la Planta Piloto de Desarrollo de Agentes de Control Biológico se han estudiado diversos microorganismos pertenecientes a los grupos de bacterias y hongos, de los cuales, se han logrado desarrollar diferentes bioinsumos con propiedades nematicidas, fungicidas e insecticidas, así como un bioestimulante, todos ellos probados a nivel de campo con excelentes resultados en el control de las plagas y rendimiento del cultivo. Sin embargo, aún se requieren esfuerzos para aumentar la disponibilidad comercial de biopesticidas microbianos, por lo cual, es necesario seguir con la búsqueda de nuevas cepas nativas eficaces en el control de enfermedades y plagas. En este aspecto la Planta Piloto de Desarrollo de Agentes de Control Biológico sigue sumando esfuerzos en el desarrollo de nuevos bioinsumos.
Referencias
- Escamilla Barragán F., Bautista García A.Y., Nava Galicia S. B. & Bibbins Martínez M. (2022). Los hongos entomopatógenos, aliados de la agricultura sustentable en el control de plagas. Frontera biotecnológica, Revista Digital del IPN, CIBA Tlaxcala - No. 23.
- Bonaterra, A., Badosa, E., Daranas, N., Francés, J., Roselló, G., & Montesinos, E. (2022). Bacteria as biological control agents of plant diseases. Microorganisms, 10(9), 1759.
- Montesinos-Matías, R., Mellin-Rosas, M. A., & Sánchez-González, J. A. (2024). Los hongos entomopatógenos endémicos de México y su uso en el control microbiano de plagas. Enfoques Transdisciplinarios: Ciencia y Sociedad, 2(2), 111-124.
Slider: Leptinotarsa texana, modelo biológico para bioensayos con agentes entomopatógenos.
Red de Biodiversidad y Sistemática
*Autor de correspondencia
